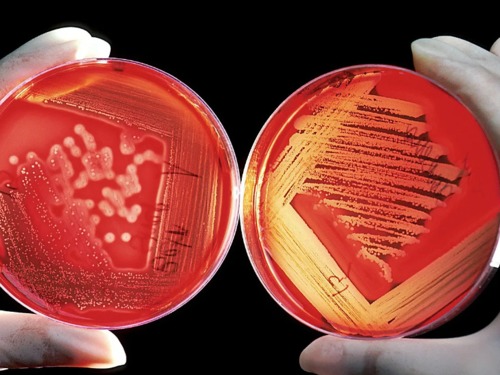

CATEGORÍA: Salud
Salmonella y Listeria, últimos casos de zoonosis en España ¿Cómo abordarlo desde la farmacia?
27 octubre 2020
En las últimas semanas se ha detectado la presencia de estas bacterias en arios productos de consumo humano.
La vacuna de Oxford contra el Covid-19 produce una fuerte respuesta inmune en los ancianos
26 octubre 2020
La vacuna contra el coronavirus que desarrolla la Universidad de Oxford con la farmecéutica AstraZeneca ha presentado sus primeros resultados de la fase 3 de ensayos clínicos.
Propuestas para vencer la resistencia bacteriana a los antimicrobianos
25 octubre 2020
Tribuna de Julio Mayol, presidente de la Sociedad Española de Investigaciones Quirúrgicas (SEIQ)
Hallan una nueva puerta de entrada del coronavirus
22 octubre 2020
Dos estudios apuntan a una vía no reconocida que facilitará el diseño de nuevas terapias antivirales contra covid-19
La española Rovi, lista para producir millones de unidades de la vacuna de Moderna a principios de 2021
21 octubre 2020
La fabricación se irá incrementando progresivamente y parece que podría tener que hacerse en campañas de vacunación recurrentes.

Farmacias abiertas y de urgencia más cercanas
Farmacias abiertas y de urgencia más cercanas